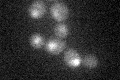
YOR358W
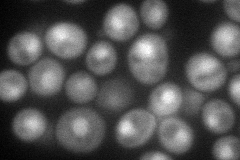
YOR358W
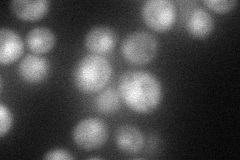
YOR358W
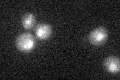
YOR358W

View description
Subunit of the heme-activated, glucose-repressed Hap2/3/4/5 CCAAT-binding complex, a transcriptional activator and global regulator of respiratory gene expression; required for assembly and DNA binding activity of the complex
Localization:
Intensity:
Fold change:
Significance:
-
C’ GFP library in SD
nucleus22.79 -
N' NOP1pr-GFP in SD
cytosol,nucleus74.7377 -
N' TEF2pr-mCherry in SD
nucleus61.4822 -
N' NATIVEpr-GFP in SD

nucleus,mitochondria22.6667 -
N' TEF2pr-VC and Cyto-VN in SD

#N/A0 -
C’ GFP library in SD+DTT

nucleus24.061.05No -
C’ GFP library in SD+H2O2
nucleus16.540.72Yes -
C’ GFP library in Starvation Media

nucleus24.71.08No -
C’ GFP library on the background of Pup2-DaMP

nucleus -
C’ GFP library on the background of CCT mutant

nucleus23.14461.01513No
